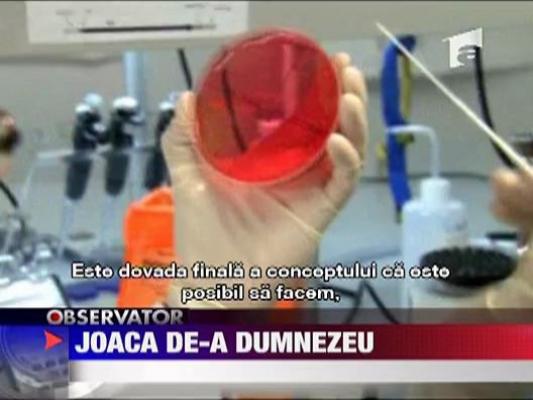
Joaca de-a Dumnezeu. Americanii au creat primul organism viu artificial

Monstru cu chip de om
Monstru cu chip de omCaz infiorator in Statele Unite, unde un tata si-a tratat in mod tiranic familia mai bine de 15 ani. Monstrul, in varsta de 47 de...
pe 08.09.2010 la 13:37
Americanii defileaza spre aur
Americanii defileaza spre aurMarea favorita la castigarea mondialului de baschet din Turcia, Statele Unite, si-a batut joc de Angola in optimi. Urmatorul meci...
pe 07.09.2010 la 21:08
Urmasul lui Spiderman
Urmasul lui SpidermanTot in spatele gratiilor a ajuns si un american care, inspirat de celebrul Spiderman, a escaladat o cladire cu 58 de etaje, din San...
pe 07.09.2010 la 16:45
Salvata de la moarte de propriul caine
Salvata de la moarte de propriul caineCainele este cel mai bun prieten al omului. Pentru o femeie din Statele Unite, animalul ei de companie este insa un adevarat erou....
pe 07.09.2010 la 14:16
Ciocnire in lant in SUA
Ciocnire in lant in SUA15 masini au fost transformate in mormane de fiare si 20 de oameni au fost raniti intr-un carambol de proportii, ce a avut loc in...
pe 07.09.2010 la 14:15
Pantalonii sus sau banii jos
Pantalonii sus sau banii josPantalonii sus sau esti bun de plata! Asta spune, pe scurt, o lege care a starnit furia tinerilor din statul american Georgia....
pe 06.09.2010 la 19:49
Salvat din infern
Salvat din infernTrei politisti americani au trecut prin foc ca sa salveze un om. Au reusit sa scoata un barbat dintr-o masina care ardea cu flacari...
pe 06.09.2010 la 19:47
Electrocutat sa nu se sinucida
Electrocutat sa nu se sinucidaUn batran bolnav a fost doborat cu socuri electrice de politisti, in propria sa casa! Oamenii legii sustin ca au dorit doar sa-l...
pe 03.09.2010 la 13:34
Omul cu doua maini noi
Omul cu doua maini noiUn american traieste o noua viata dupa ce i s-au transplantat ambele maini, in locul celor care-i fusesera distruse de un grav...
pe 03.09.2010 la 08:08
Ucigasul misterios
Ucigasul misteriosPolitistii din California se confrunta cu un caz incredibil. Un om barbat impuscat mortal s-a dovedit a fi un criminal in serie,...
pe 02.09.2010 la 07:52
Ostatici la Discovery Chanel
Ostatici la Discovery ChanelMomente dramatice ieri la sediul postului Discovery, unde un ecologist a luat ostatici mai multi oameni. Dupa 4 ore a fost ucis de...
pe 02.09.2010 la 07:50
Americanii au incheiat, oficial, razboiul din Irak
Americanii au incheiat, oficial, razboiul din IrakLa peste 7 ani de la declansarea conflicutului, majoritatea militarilor s-au intors acasa. Iar liderul de la Casa Alba, Barack...
pe 01.09.2010 la 19:45
Noua "fata" a Biroului Oval
Noua "fata" a Biroului OvalSi schimbari la Casa Alba. Nu se schimba presedintele, ci biroul lui. De la tapet, flori si chiar canapele, totul a fost modificat...
pe 01.09.2010 la 16:46
Aniversare la inaltime
Aniversare la inaltimeMergem acum in Statele Unite, unde un grup de pensionari a ales sa-si aniverseze cei 52 de ani de la terminarea liceului intr-un mod...
pe 31.08.2010 la 16:39
Razboiul baloanelor cu apa
Razboiul baloanelor cu apaDistractie pe cinste in Statele Unite unde cinci mii de tineri au incercat sa intre in Cartea Recordurilor si sa se. racoreasca in...
pe 30.08.2010 la 13:58
Transplant de maini in SUA
Transplant de maini in SUAMedicii din statul american Louisville au terminat cu succes al treilea transplant de mâini din SUA. Operatia a durat peste 17 ore,...
pe 29.08.2010 la 09:33
Cu viteza spre moarte
Cu viteza spre moarteIn Statele Unite setea de adrenalina a impins un tanar de 19 ani in pragul mortii. La volanul unei masini mult prea puternice pentru...
pe 25.08.2010 la 19:49
Ajutor de serif, sechestrat de un roi de albine
Ajutor de serif, sechestrat de un roi de albineUn ajutor de serif din Statele Unite a fost sechestrat de. un roi de albine. Mii de insecte s-au napustit asupra masinii barbatului,...
pe 19.08.2010 la 13:49
Escrocherie de sute de mii de dolari in SUA
Escrocherie de sute de mii de dolari in SUAO romanca si doi complici sunt banuiti de o mega-escrocherie, in Statele Unite. Cei trei sunt acuzati ca ar fi deturnat peste 800 de...
pe 19.08.2010 la 13:27
Ultima brigada americana de lupta s-a retras, azi-noapte, din Irak
Ultima brigada americana de lupta s-a retras, azi-noapte, din IrakUltima brigada americana de lupta s-a retras, in aceasta noapte, din Irak, la aproape sapte ani si jumatate de la interventia...
pe 19.08.2010 la 07:50
Cel mai greu rol
Cel mai greu rolActorul Michael Douglas este macinat de boala. Cancerul i-ar putea lua, pentru totdeauna, vocea, si, odata cu ea, posibilitatea de...
pe 18.08.2010 la 19:43
Mama ucigasa
Mama ucigasaAmericanii sunt ingroziti de o crima greu de inchipuit. O femeie a recunoscut ca si-a ucis doi dintre copii, in varsta de un an si...
pe 18.08.2010 la 08:13
Relaxare de presedinte
Relaxare de presedintePresedintele american imbina utilul cu placutul. Barack Obama si-a petrecut vacanta in zona afectata de poluarea cu petrol. A facut...
pe 15.08.2010 la 19:40
A facut sacrificiul suprem pentru fratele sau
A facut sacrificiul suprem pentru fratele sauUn american a facut sacrificiul suprem, pentru fratele lui. S-a oferit sa-i doneze o bucata de ficat, pentru ca stia ca, altfel,...
pe 15.08.2010 la 19:38
Un sarut pentru istorie
Un sarut pentru istorieImplinirea a 65 de ani de la sfarsitul celui de-al doilea razboi mondial a fost sarbatorita cu saruturi in Statele Unite
pe 15.08.2010 la 16:35
Lectia de generozitate
Lectia de generozitateO femeie din Statele Unite a avut incredere sa-i dea unui cersetor un card pentru a-si cumpara apa plata. In fne, cersetorul i-a...
pe 14.08.2010 la 16:28
Week-end tabloid - 13 august
Week-end tabloid - 13 augustEra o vreme cand Lili Sandu spunea ca vrea sa plece cat mai departe de Romania. S-a urcat in avion si dusa a fost in Statele Unite....
pe 13.08.2010 la 19:49
Succes peste ocean
Succes peste oceanMedicii romani vor si ei sa fie la curent cu tot ce-i nou in domeniu. In tarile dezvoltate, in fiecare saptamina e ceva nou. Pentru...
pe 12.08.2010 la 19:04
Un motan plimbat
Un motan plimbatUn motan din Statele Unite este considerat cel mai norocos din lume. Felina, care nu vede a disparut de la adapostul in care era...
pe 11.08.2010 la 13:49
A trait cu un bob de mazare in plamani
A trait cu un bob de mazare in plamaniA trait luni intregi cu un bob de mazare care ii crestea in plamani! Este povestea unui batran din Statele Unite care a crezut...
pe 11.08.2010 la 13:47
Neglijenta criminala
Neglijenta criminalaArmele lasate nesupravegheate prin casa si neglijenta parintilor pot duce la tragedii. Un copil de sase ani din Washington s-a...
pe 11.08.2010 la 13:45
A evacuat un avion pentru ca l-a suparat un pasager
A evacuat un avion pentru ca l-a suparat un pasagerUn insotitor de bord din Statele Unite a evacuat un avion pentru ca s-a enervat. Stewardul le-a cerut pasagerilor sa nu isi...
pe 10.08.2010 la 13:51
Prea devreme la pubertate
Prea devreme la pubertateProblema obezitatii in Statele Unite se agraveaza. Potrivit unui studiu recent, copiii obezi ajung mult mai devreme la pubertate....
pe 10.08.2010 la 13:34
Nebuna dupa fast-food
Nebuna dupa fast-foodPasiunea pentru fast-food a unei femei din Statele Unite a dus-o direct la inchisoare. Americanca a luat la bataie o vanzatoare...
pe 10.08.2010 la 13:33
Incediu de proportii intr-un cartier rezidential din LA
Incediu de proportii intr-un cartier rezidential din LAUn incendiu banal se putea transforma intr-o tragedie in Statele Unite. Interventia tarzie a pompierilor a facut ca mai multe case...
pe 09.08.2010 la 13:38
Sezonul tornadelor in Statele Unite
Sezonul tornadelor in Statele UniteStatele Unite ale Americii au fost lovite de tornade. Cele mai afectate regiuni au fost Dakota de Nord si Minnesota.
pe 09.08.2010 la 09:30
Cum sa scapi de miliarde, dupa model american
Cum sa scapi de miliarde, dupa model americanDoamnelor si domnilor, bogatia nu e pentru toti cum nici fericirea nu binecuvinteaza pe oricine. 40 de americani, si bogati, si...
pe 06.08.2010 la 18:58
Obama, singur de ziua lui
Obama, singur de ziua luiCeva e putred la Casa Alba. Cam asta a fost in mintea tuturor americanilor, cand au aflat ca, de ziua lui, presedintele Barack Obama...
pe 05.08.2010 la 19:46
Si-a salvat viata tastand un mesaj de ajutor cu picioarele
Si-a salvat viata tastand un mesaj de ajutor cu picioareleO femeie din Statele Unite si-a salvat viata pentru ca isi coordonează foarte bine picioarele. Dupa ce un hot i-a patruns in casa,...
pe 04.08.2010 la 08:10
Masacru la o companie de distributie din Statele Unite
Masacru la o companie de distributie din Statele UniteNoua oameni au fost omorati. Un sofer care urma să fie concediat a deschis focul asupra colegilor sai, dupa care s-a sinucis.
pe 04.08.2010 la 08:08
A fost filmat in timp ce fura caini dintr-un PetShop
A fost filmat in timp ce fura caini dintr-un PetShopJafurile sunt la ordinea zilei in Statele Unite iar politistii nu mai sunt usor de surprins. Cu toate acestea, un hot din Houston a...
pe 03.08.2010 la 13:43
Ploaie cu grindina uriasa in Statele Unite ale Americii!
Ploaie cu grindina uriasa in Statele Unite ale Americii!In Dakota de Sud au cazut bucati de gheata de peste un kilogram si au facut praf totul: acoperisuri, masini. Oficialii americani...
pe 02.08.2010 la 13:48
Chelsea Clinton s-a maritat
Chelsea Clinton s-a maritatOchii americanilor au fost atintiti ieri asupra micului orasel din apropierea New Yorkului, acolo unde a avut loc nunta anului....
pe 01.08.2010 la 08:56
Reclamata de propria fiica
Reclamata de propria fiicaO femeie din Statele Unite s-a ales cu dosar penal din cauza fiicei sale. Grijulie din fire, fata a sunat la numarul de urgenta,...
pe 28.07.2010 la 13:46
Durere si resemnare pentru doua familii din Statele Unite
Durere si resemnare pentru doua familii din Statele UniteDoua familii indurerate, o tanara care se zbate intre viata si moarte si una care a pierdut lupta. Sunt ingredientele unui complicat...
pe 27.07.2010 la 13:37
SUA: O tornada insotita de ploi abundente a lovit statul Iowa
SUA: O tornada insotita de ploi abundente a lovit statul IowaNatura a facut o demonstratie de forta si in Statele Unite. Mai exact in statul Iowa, unde o tornada insotita de ploi abundente, a...
pe 26.07.2010 la 13:36
Record de longevitate: are 114 ani!
Record de longevitate: are 114 ani!Nu stim ce a mancat, cert este ca a ajuns la venerabila varsta de 114 ani si se tine inca foarte bine. Vorbim despre o femeie din...
pe 26.07.2010 la 08:25
Exercitii militare comune intre SUA si Coreea de Sud
Exercitii militare comune intre SUA si Coreea de SudWashingtonul si Seulul au demarat, ieri, o serie de exercitii militare comune, cu intentia declarata de a transmite un avertisment...
pe 26.07.2010 la 07:55
Dezvaluiri socante legate de ororile razboiului din Afganistan
Dezvaluiri socante legate de ororile razboiului din AfganistanDezvaluiri socante legate de ororile razboiului din Afganistan. Un site specializat in anchete a intrat in posesia unor documente...
pe 26.07.2010 la 07:51
Ranit grav de un pantof cu toc cui
Ranit grav de un pantof cu toc cuiUn american ar putea ramane fara un ochi dupa ce a fost grav ranit de un pantof cu toc cui. Barbatul a fost atacat, fara vreun motiv...
pe 21.07.2010 la 07:56

